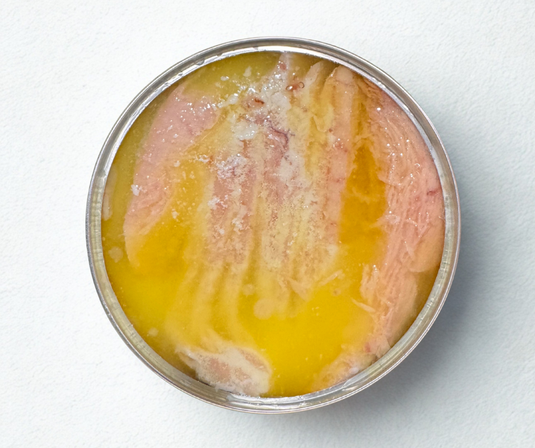

Colecciones
Add a brief introduction to the page.
-

Los más vendidos de Intershell
Not sure where to start? Let our customers guide you. This collection...
-

Mariscos congelados
Premium frozen shellfish, harvested at peak freshness and flash-frozen to lock in...
-

Todos los peces
The complete Intershell Seafood fish selection in one place. From wild-caught New...